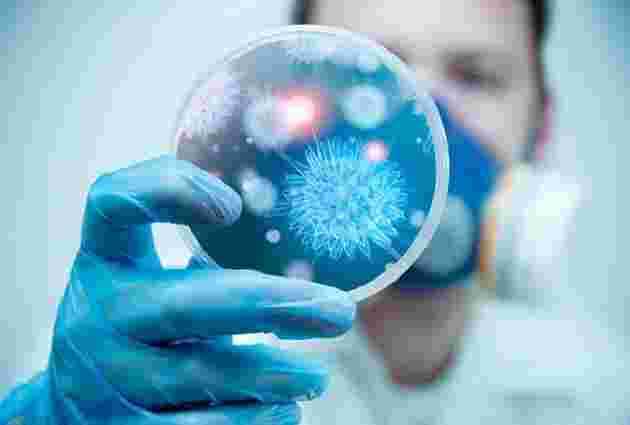

Міністерство охорони здоров’я підтвердило спалах поліомієліту в Україні
До теми
Лабораторія, сертифікована Всесвітньою організацією охорони здоров'я підтвердила, що захворювання двох дітей на Закарпатті було спричинено вірусом, що відповідно до Міжнародних медико-санітарних правил прирівнюється до спалаху поліомієліту. Про це повідомила 3 вересня прес-служба Міністерства охорони здоров’я України.
«Циркуляція такого вірусу ставить під загрозу всіх нещеплених дітей в Україні. У зв’язку з чим наполягаємо на посиленні епіднагляду по всій території України, взяття додаткових проб у всіх, хто контактував з дітьми на Закарпатті. Було прийнято рішення про створення Оперативного штабу з реагування та протидії розповсюдженню захворювання, куди запрошені представники міжнародних організацій ВОЗ та ЮНІСЕФ», – повідомили у Мінохорони здоров’я.
В українському відомстві зазначили, що випадки циркуляції вірусу поліомієліту похідного від вакцинного штаму є рідкісними, проте очікувані у країнах з великою кількістю невакцинованих груп населення.
«Рівень охоплення вакцинацією дітей проти поліо в Україні є вкрай низьким – за минулий рік лише 49%, за перше півріччя цього року - 14,1%. МОЗ нагадує, що вакцина для проведення імунізації дітей вже є в Україні», – наголосили в МОЗ.
Не пропустіть найважливіше Додайте ZAXID.NET у вибрані в GoogleЗазначено, що уряд Канади за підтримки Дитячого фонду ООН (ЮНІСЕФ) закупив 3,7 млн доз вакцини. Перша партія вакцин (ОПВ – 1,5 млн доз) вже надійшли в Україну, друга партія має надійти найближчим часом.
Також Міністерство охорони здоров’я звернуло увагу батьків на більш уважному ставленні до питання імунопрофілактики дітей.
Як повідомляв ZAXID.NET, 1 вересня лабораторія Всесвітньої організації охорони здоров’я (ВООЗ) заявила, що виявила поліовірус cVDPV1 (поліомієліт) у двох дітей із Закарпатської області. На момент виявлення паралічу одній дитині було чотири роки, другій – 10 місяців; обидві дитини попередньо не вакциновані від поліомієліту.
Наступного дня, 2 вересня, начальник головного управління Держсанепідслужби у Закарпатській області Володимир Маркович заперечив інформацію про спалах поліомієліту в області. За його словами медики здійснили лабораторні дослідження, які показали, що поліомієліту в них немає.
Між тим, головний лікар обласної клінічної інфекційної лікарні Михайло Поляк зазначив, що за 2015 рік в Закарпатську область було поставлено імунобіологічних препаратів 14,9% від загальної потреби регіону.
Зазначимо, поліомієліт – гостре інфекційне захворювання, яке зумовлене поліовірусом та здатне перебігати з ураженням центральної нервової системи, з виникненням парезів і паралічів, закінчуючись смертю інфікованого.














